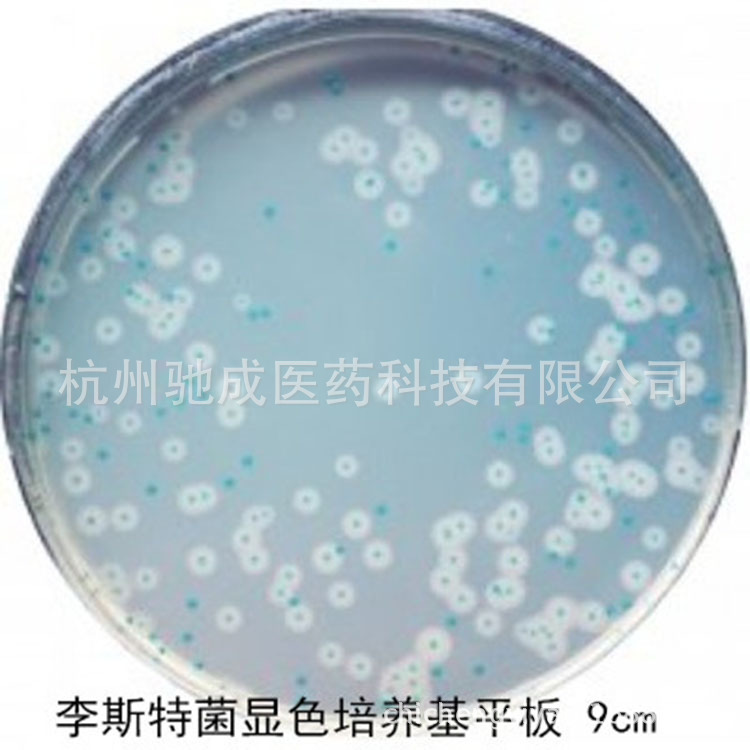
科玛嘉 李斯特氏菌显色培养基平板 9cm 10只/包 即用型平皿

1688工业品为您提供在线免费查询更多化学试剂详细参数、实时报价、规格一览表。更多关于化学试剂多少钱一瓶/化学试剂报价明细/化学试剂规格型号价格表/化学试剂批发市场价格/化学试剂官方报价等咨询,尽在1688工业品。询底价>
为你找到生化试剂相关产品

实验试剂 Gentihold原装 甘油 丙三醇 G1388-100ML
广东深圳
在线询价

盐酸罗沙替丁醋酸酯/93793-83-0/源叶 B27065/Roxatidine acetate
上海
在线询价

大量现货供应 次黄嘌呤/6-羟基嘌呤 68-94-0
江苏苏州
在线询价
![实验试剂 维生素B12[氰钴胺素] 维生素乙B12 氰钴胺 维他命B12](https://cbu01.alicdn.com/img/ibank/2016/560/088/2857880065_717641700.jpg)
实验试剂 维生素B12[氰钴胺素] 维生素乙B12 氰钴胺 维他命B12
广东深圳
在线询价

3,4,7-三羟基异黄酮/485-63-2/源叶 B24254/3,4,7-Trihydroxyis
上海
在线询价

M0050 HPD300大孔吸附树脂 Macroporous Adsorption Resin 科研用
北京
在线询价

茯苓酸A/137551-38-3/源叶 B25591/poricoic acid A/HPLC≥96% 标
上海
在线询价
科玛嘉 李斯特氏菌显色培养基平板 9cm 10只/包 即用型平皿
浙江杭州
在线询价

D-组氨酸 ≥99% 科研实验试剂CAS:351-50-8
安徽合肥
在线询价

大量现货供应 胎牛血清
江苏苏州
在线询价

白麻苷/18609-17-1/源叶 B20048/Quercetin-3-O-sophoroside/HPLC
上海
在线询价

吡哆醇盐酸盐(VB6;维生素B6盐酸盐),科研试剂 CAS:58-56-0
北京
在线询价
查看更多产品及报价
100+生化试剂相关产品等你解锁
AI找工业3000行家正在找货
AI找品,免费询价,源头正品,上1688工业品,全国的工业正品交易平台




